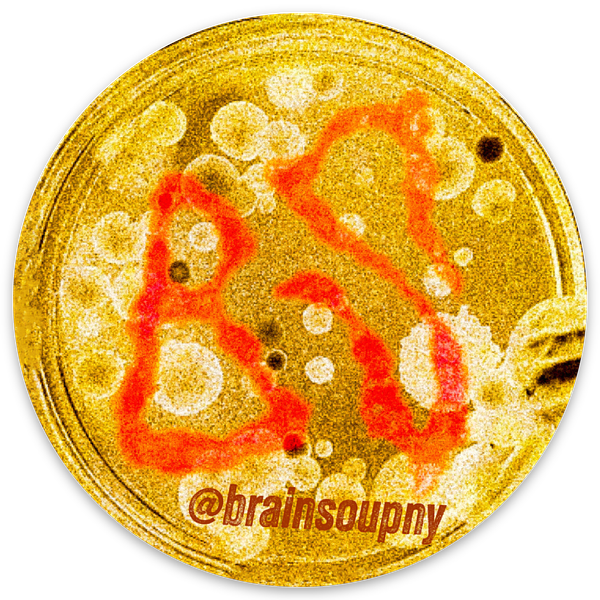

29C08228 7B13 4E5E A0CD C874F1DAF78C

Custom hats by Brain Soup
More from Brain Soup
BS Sticker
Circle stickers
78D95F6C 1289 4F02 A974 6F4F33B5D4F0
Circle stickers
Brain Soup Sticker
Holographic stickers
Reviews for custom hats
4.3 / 5
255
Total reviews
82%
Would order again
 Paul Alvarez
Paul AlvarezI had 2 hats done and while the quality of the print was excellence, I noticed variation in the registration, meaning it was centered and then one wasn’t so centered. Had they been important I may have complained but it wasn’t off enough to make a big deal of it.
 Cowiche Canyon
Cowiche CanyonWith your company- I tell everyone I know about you guys thank you again
- KPKevin Parrella
Everything about ordering, from beginning to end was easy and fast. The hat quality is great as was the design help to get to the final product! Love it.

- MF

Comments